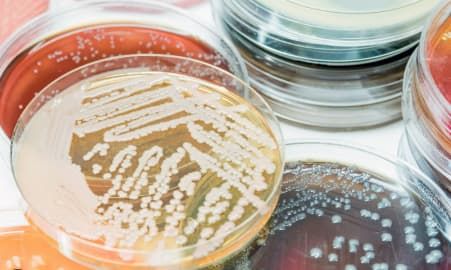
Testing and reading materials - Water Restoration in North Queensland

Cleaners Yeppoon
Our Services
Specialised Cleaning & Restoration Services in Yeppoon
For over 38 years, Revive Cleaning & Restoration has been providing a comprehensive range of expert cleaning and specialised restoration solutions to commercial clients across Central Queensland.
Whether it’s for an office, factory or following a major event like a Cyclone – our trusted team of qualified technicians pride themselves on getting the job done. We are on hand 24/7 for emergency responses.
We serve clients throughout Central Queensland, including Yeppoon, Rockhampton, Gladstone, Biloela, Emerald and surrounding areas.
Have a browse through our previous projects, and see for yourself the level of work that we put into every job we take on.
From carpet cleaning and stain removal to disaster management and crime scene and trauma clean-ups, you can rest easy knowing Revive Cleaning & Restoration can take on any job.
Ready to get your property back on deck?
Call us on
07 4939 7377 or
get a quote today!
- 24/7 Water Damage Restoration
- Emergency Cleaning
- Drying & Dehumidification
- Carpet Cleaning
- Specialised Commercial Cleaning
- Fire Damage
- Mould Remediation
- Structural Drying
- Thermal Imaging
- Air Quality Testing
- Sewage – Bio Hazard Decontamination
- Crime and Trauma Scene Clean-Up
- Methamphetamine Testing
- Methamphetamine Decontamination
- Sanitising & Odour Control
- Electrical make-safes
- Upholstery and Rug Cleaning
Comprehensive Cleaning & Restoration Solutions
Revive Cleaning & Restoration is your one-stop destination for specialised cleaning services and disaster recovery solutions. Whether you require routine commercial cleaning, urgent water extraction or a thorough post-fire cleanup, our team is equipped to handle it all. As experienced cleaners in Yeppoon, we’ve assisted businesses, factories and organisations across Central Queensland for over 38 years. We take pride in not only maintaining high standards of cleanliness but also providing an essential line of support when disasters strike. From carpet cleaning in Yeppoon offices and commercial premises to large-scale restoration projects, we guarantee reliable, top-quality work for every job we take on.
Reliable Commercial Cleaning
A clean, well-maintained environment is crucial to the success of any business. Whether you manage an office, warehouse, retail space or educational facility, our commercial cleaning services cover regular upkeep, specialised carpet cleaning in Yeppoon for high-traffic areas and the restoration of hard surfaces like tile and concrete. We use state-of-the-art cleaning equipment and industry-approved processes to effectively remove dirt, stains and potential health hazards from your premises. With 24/7 availability, our skilled technicians work around your schedule to minimise disruption, ensuring your operations continue smoothly.
Specialised Restoration & Recovery
When properties are affected by fire, floods, trauma or biohazard incidents, professional expertise is critical for safe restoration. Revive Cleaning & Restoration has extensive experience in restoring workplaces following emergencies, from rapid water extraction to smoke and soot cleanup. As leading cleaners in Yeppoon, we step in to manage sanitation, debris removal and deep-cleaning tasks that bring your site back to its original condition—if not better.
24/7 Emergency Response for Water & Fire Damage
Disasters rarely strike at convenient times, which is why Revive Cleaning & Restoration operates a round-the-clock emergency response. The quicker we arrive on-site, the more effectively we can minimise damage, reduce overall costs and help you resume normal operations. Whether it’s a burst pipe in the middle of the night or fire damage at daybreak, we’re just a phone call away—ready to stabilise your property and start the restoration process.
Fast & Effective Water Damage Restoration
Water damage can compromise walls, floors, furniture and even structural elements if not dealt with immediately. Our specialists provide urgent water extraction, structural drying and dehumidification to halt the spread of moisture. We use advanced monitoring equipment to locate hidden water pockets, ensuring the complete removal of damp areas. By using these proven methods, we help prevent mould growth and unpleasant odours, safeguarding both your property’s integrity and occupant health.
Comprehensive Fire Damage Cleanup
After a
fire incident, dealing with soot, smoke odours and structural damage can feel overwhelming. We handle everything from initial debris removal to complete smoke remediation, odour neutralisation and redecoration if needed. By meticulously cleaning surfaces, HVAC systems and furnishings, we eliminate any lingering traces of burnt materials. Our team’s long-standing experience as cleaners in Yeppoon ensures that each property we restore regains a safe, habitable environment as promptly as possible.
Advanced Mould Remediation & Testing Services
Mould poses serious health risks and can undermine the structure of a property if not resolved quickly. Revive Cleaning & Restoration offers specialised mould remediation services founded on industry best practices and cutting-edge technology. We systematically identify and eradicate mould growth, while also addressing the root causes that allow it to flourish, such as excess humidity or water intrusion. Our goal is to keep your building mould-free, safeguarding both occupants and structures.
Thorough Mould Testing & Inspection
Determining the severity of a mould problem starts with meticulous testing. We collect air and surface samples to measure spore counts, identify mould species and locate hidden colonies. Our detailed inspection goes beyond obvious signs like discolouration or musty smells, ensuring no contaminated area remains overlooked. This data-driven approach shapes our remediation plan, guaranteeing personalised strategies that effectively address any underlying moisture issues.
Cutting-Edge Mould Remediation
Removal alone is not sufficient—true remediation calls for eliminating both visible mould and dormant spores. We employ advanced containment techniques, high-efficiency air filtration devices and eco-friendly cleaning solutions to restore safe indoor conditions. Each project concludes with a final clearance test to confirm the success of our work. By preventing mould’s recurrence, we protect your health and maintain your property’s value over the long term.
Expert Carpet, Upholstery & Floor Cleaning
Commercial carpets, tiled floors and upholstery endure heavy daily use, collecting dust, stains and allergens that vacuuming alone cannot fully remove. As highly skilled cleaners in Yeppoon, we offer professional deep-cleaning solutions that restore floors and furniture to like-new condition. Our specialised techniques are proven to prolong product lifespan, improve indoor air quality and revitalise the appearance of your premises.
Superior Carpet & Upholstery Cleaning
Revive Cleaning & Restoration performs carpet cleaning in Yeppoon using powerful steam extraction or low-moisture methods, depending on the material and environment. We target embedded dirt and pathogens, tackling everything from tough coffee stains to pet odours. Our upholstery cleaning follows similar principles, with equipment specifically calibrated for delicate fabrics. By removing pollutants and allergens, we ensure healthier, fresher interiors for staff, customers and visitors.
Effective Hard Surface Restoration
Hard floors such as tile, concrete and vinyl often lose their shine over time, accumulating grime in grout lines or surface pores. Our intensive cleaning rejuvenates these surfaces, lifting away embedded contaminants. We can also apply sealants or specialised coatings to shield the floor from future wear, moisture penetration or staining. Paired with our carpet cleaning in Yeppoon, our versatile hard surface services give your entire property a consistent, well-cared-for look.
Large Loss & Disaster Management Specialists
Major events such as cyclones, storms and extensive flooding can leave commercial and industrial facilities in disarray. Our large loss management services cater to high-impact projects, ensuring efficient and organised restoration. Because we’re accustomed to deploying rapid solutions in adverse conditions, we’re able to provide stabilisation, debris removal and reconstruction support to help businesses bounce back swiftly. You can count on Revive Cleaning & Restoration’s strategic approach and high-capacity resources whenever catastrophe strikes.
Rapid Response to Cyclones & Natural Disasters
Situated in Central Queensland, we know how unpredictable storms and cyclones can be. Our team mobilises quickly following major weather events, supplying critical assistance such as water extraction, mould control and structural drying. By initiating immediate interventions, we limit damage, protect salvageable items and kick-start the recovery process. We also collaborate with insurers and local authorities, ensuring a smooth path to rebuilding your property.
Minimising Downtime & Losses
Every hour of downtime is costly, especially for large commercial or industrial sites. Our organised cleaning and restoration strategies aim to get your operations back on track quickly, thereby reducing disruption to employees, customers and revenue. We coordinate each phase meticulously—from cleanup and drying to final sanitisation—so you can focus on business continuity. Whether you need immediate carpet cleaning in Yeppoon after a water intrusion or large-scale restoration following a cyclone, we’re equipped to handle every aspect.
Advanced Equipment & Industry Expertise
At Revive Cleaning & Restoration, our commitment to excellence is evident in our continual investment in leading technology, high-calibre training and strict adherence to recognised global standards. From removing stubborn stains in an office to carrying out full-scale building restoration, each project benefits from our refined processes and professional oversight. We’ve built our reputation on providing results that stand the test of time.
State-of-the-Art Restoration Equipment
We use cutting-edge machinery for extraction, drying, microbial decontamination and more. Infrared cameras assist in detecting concealed water damage, while powerful dehumidifiers and air movers halt mould proliferation. Our advanced cleaning gear tackles even the toughest stains on carpets, upholstery and floors. By pairing the right tool with the right method, we achieve consistent, high-quality outcomes.
Certified & Experienced Technicians
Our technicians are fully certified, regularly attending industry training to keep current with the newest techniques and regulations. This expertise, combined with our decades-long presence as cleaners in Yeppoon, provides clients with a dependable team prepared for any challenge. Whether you need carpet cleaning in Yeppoon for a small office or a comprehensive restoration after a disaster, we’ll deliver exemplary service with minimal disruption.
Get in touch today to discover how Revive Cleaning & Restoration can transform and protect your property. We serve Yeppoon, Rockhampton, Gladstone, Biloela, Emerald and the broader Central Queensland region, providing 24/7 services when you need them most. Whether it’s a straightforward maintenance task or large-scale post-disaster recovery, our unwavering commitment to quality shines through. Call us on (07) 4939 7377 for a free quote or to learn more about how we can help secure, clean and restore your premises. We look forward to being your cleaners in Yeppoon.
Mould Testing & Remediation
Revive Cleaning & Restoration sets the benchmark in mould remediation by applying cutting-edge technology, advanced procedures, and adhering to industry standards. We tackle mould growth and the root causes effectively.
We conduct thorough testing to identify and assess the extent of mould presence in your property. We follow the guidelines set by the IICRC to ensure our work aligns with industry best practices.
Simply get in touch to speak to a member of our team and find out how we can help you.
Why Choose Revive Cleaning & Restoration?
Revive Cleaning & Restoration is a trusted and well-established specialised service provider in Yeppoon. Choosing our company will provide you with peace of mind that the job will be done right every time thanks to our skilled and knowledgeable team.
With an emphasis on high standards, our staff are well-versed in getting any commercial property back to looking its best through our remediation and restoration services of disaster recovery cleaning, including following fires or floods, and more.